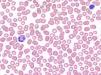
fig0015

Presentamos el caso de una mujer de 37 años, natural de Panamá, residente en España desde hace 18 años, que acudió al Servicio de Urgencias por síndrome febril de 7 días de evolución, tras regresar de un viaje a su país de origen en las dos semanas previas. El cuadro se acompañaba de intensa cefalea de predominio retroocular, artromialgias y astenia.
A las 24 horas desarrolló un exantema en los miembros inferiores asociado a disestesias plantares que requirió valoración por parte del Servicio de Dermatología.
Exploración físicaSe objetivó la presencia de un exantema petequial sobre base eritematosa, destacando la existencia de pequeñas áreas cutáneas indemnes, afectando a las piernas, el dorso de los pies y el arco plantar interno, sin una correcta delimitación de las lesiones (figs. 1 y 2).
Pruebas complementariasSe realizó una analítica general que mostró leucopenia, trombopenia e hipertransaminasemia, con parámetros hemostáticos normales. El frotis de sangre periférica confirmó la trombopenia, en ausencia de agregados plaquetarios y elementos parasitarios (fig. 3).
Se solicitaron serologías para el virus de Epstein-Barr, citomegalovirus, virus de la hepatitis A, B, C, VIH, parvovirus B19, leishmania, gota gruesa, determinación de antigenemia para Plasmodium falciparum y PCR para virus dengue.
¿Cuál es su diagnóstico?
DiagnósticoDengue clásico.
Evolución y tratamientoMediante la administración de paracetamol intravenoso y de sueroterapia, la paciente permaneció afebril y hemodinámicamente estable. No presentó signos de sangrado activo ni progresión de las lesiones purpúricas en los miembros inferiores, siendo dada de alta por mejoría clínica. La presencia de ARN del flavivirus causante del dengue se demostró en sangre periférica.
DiscusiónEl dengue es la enfermedad por arbovirus más importante en humanos. Está causada por un flavivirus y se transmite por la picadura de los mosquitos Aedes aegypti y, en menor medida, Aedes albopictus, que habitan en áreas tropicales y subtropicales de Centroamérica, África subsahariana y sudeste asiático.
La infección por cada uno de los serotipos del virus se asocia a inmunidad permanente.
La OMS clasifica la sintomatología del dengue en tres grandes síndromes: el dengue clásico y las variantes potencialmente más graves, la fiebre hemorrágica por dengue y el síndrome de shock por dengue1. El desarrollo de estas dos últimas se produce con mayor frecuencia en individuos reinfectados por un serotipo vírico distinto al de la primoinfección. Este suceso se encuentra probablemente relacionado con la aparición de una respuesta inmunitaria heteróloga frente al nuevo serotipo, por la que el sistema inmunológico queda “atrapado” por la primera respuesta frente al serotipo antiguo y es incapaz de generar respuestas más eficaces durante las posteriores reinfecciones (efecto Hoskins)2.
Clínicamente, el dengue clásico se caracteriza por la tríada: fiebre, cefalea retroocular y artromialgias (tradicionalmente denominada “fiebre quebrantahuesos”), acompañándose en el 50-80% de los casos de afectación cutánea.
En las primeras 24-48 horas se aprecia un eritema difuso en el área facial, cervical y torácica (flushing), que los viajeros procedentes de áreas endémicas suelen atribuir, de forma errónea, a los efectos de la exposición solar continuada. A los 3-5 días aparece un exantema maculoeritematoso, morbiliforme, de extensión variable, sobre el que asientan petequias; en su interior, además, se encuentran áreas de piel respetada, conformándose lo que característicamente se denominan “islas blancas sobre mar rojo”3.
El diagnóstico se basa en criterios clínicos, hallazgos de laboratorio (leucopenia, trombopenia, hipertransaminasemia), confirmándose mediante técnicas moleculares (PCR de ARN viral) o serológicas (presencia de IgM o aumento de cuatro veces en el título de IgG específica). El estudio anatomopatológico cutáneo no arroja datos concluyentes, mostrando vasos dilatados congestivos, un infiltrado inflamatorio linfohistiocitario perivascular y extravasación hemática4.
En el diagnóstico diferencial deben incluirse otras fiebres hemorrágicas virales (fiebre de Lassa, Ébola, Arenavirus americanos), malaria, fiebre de Chikungunya, fiebre tifoidea, exantema súbito, eritema infeccioso y síndromes mononucleósicos, entre otros5.
El tratamiento se basa en la instauración de medidas de soporte hemodinámico y en la administración de analgésicos antitérmicos. Debe evitarse el uso de ácido acetil salicílico por la posibilidad de complicaciones hemorrágicas o, más raramente, de desarrollo de síndrome de Reye.
Finalmente, las estrategias de prevención de la enfermedad se centran en la erradicación de Aedes aegypti y en el desarrollo de una vacuna tetravalente efectiva que, por el momento, permanece en fase experimental.
Conflicto de interesesLos autores declaran no tener ningún conflicto de intereses.